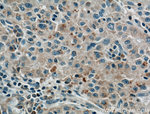
LPCAT1 Antibody in Immunohistochemistry (Paraffin) (IHC (P))

Search
Proteintech
LPCAT1 Monoclonal Antibody (8B6E9)
{{$productOrderCtrl.translations['antibody.pdp.commerceCard.promotion.promotions']}}
{{$productOrderCtrl.translations['antibody.pdp.commerceCard.promotion.viewpromo']}}
{{$productOrderCtrl.translations['antibody.pdp.commerceCard.promotion.promocode']}}: {{promo.promoCode}} {{promo.promoTitle}} {{promo.promoDescription}}. {{$productOrderCtrl.translations['antibody.pdp.commerceCard.promotion.learnmore']}}
产品信息
66044-1-IG
种属反应
已发表种属
宿主/亚型
分类
类型
克隆号
抗原
偶联物
形式
浓度
规格
纯化类型
保存液
内含物
保存条件
运输条件
产品详细信息
Immunogen sequence: IKRRAQSNG KWPQIMIFPE GTCTNRTCLI TFKPGAFIPG APVQPVVLRY PNKLDTITWT WQGPGALEIL WLTLCQFHNQ VEIEFLPVYS PSEEEKRNPA LYASNVRRVM AEALGVSVTD YTFEDCQLAL AEGQLRLPAD TCLLEFARLV RGLGLKPEKL EKDLDRYSER ARMKGGEKIG IAEFAASLEV PVSDLLEDMF SLFDESGSGE VDLRECVVAL SVVCRPARTL DTIQLAFKMY GAQEDGSVGE GDLSCILKTA LGVAELTVTD LFRAIDQEEK GKITFADFHR FAEMYPAFAE EYLYPDQTHF ESCAETSPAP IPNGFCADFS PENSDAGRKP VRKKLD (51-395 aa encoded by BC020166)
靶标信息
PCAT1 acyltransferase (LPCAT; EC 2.3.1.23) catalyzes the conversion of LPC to hosphatidylcholine (PC) in the remodeling pathway of PC biosynthesis.
仅用于科研。不用于诊断过程。未经明确授权不得转售。
生物信息学
蛋白别名: 1-acylglycerol-3-phosphate O-acyltransferase; 1-acylglycerophosphocholine O-acyltransferase; 1-alkenylglycerophosphocholine O-acyltransferase; 1-alkylglycerophosphocholine O-acetyltransferase; Acetyl-CoA:lyso-PAF acetyltransferase; Acetyl-CoA:lyso-platelet-activating factor acetyltransferase; acyl-CoA:lysophosphatidylcholin; acyltransferase like 2; Acyltransferase-like 2; LPC acyltransferase 1; LPCAT-1; lyso-PAF acetyltransferase; lysoPAFAT; lysoPC acyltransferase 1; Lysophosphatidylcholine acyltransferase 1; lysophospholipid acyltransferase 8; mLPCAT1; Phosphonoformate immuno-associated protein 3; unnamed protein product
基因别名: 2900035H07Rik; AGPAT10; AGPAT9; AYTL2; BB137372; BC005662; C87117; LPCAT; LPCAT-1; LPCAT1; LPLAT8; lysoPAFAT; PFAAP3; rd11; RGD1311599
UniProt ID: (Human) Q8NF37, (Mouse) Q3TFD2, (Rat) Q1HAQ0
Entrez Gene ID: (Human) 79888, (Mouse) 210992, (Rat) 361467